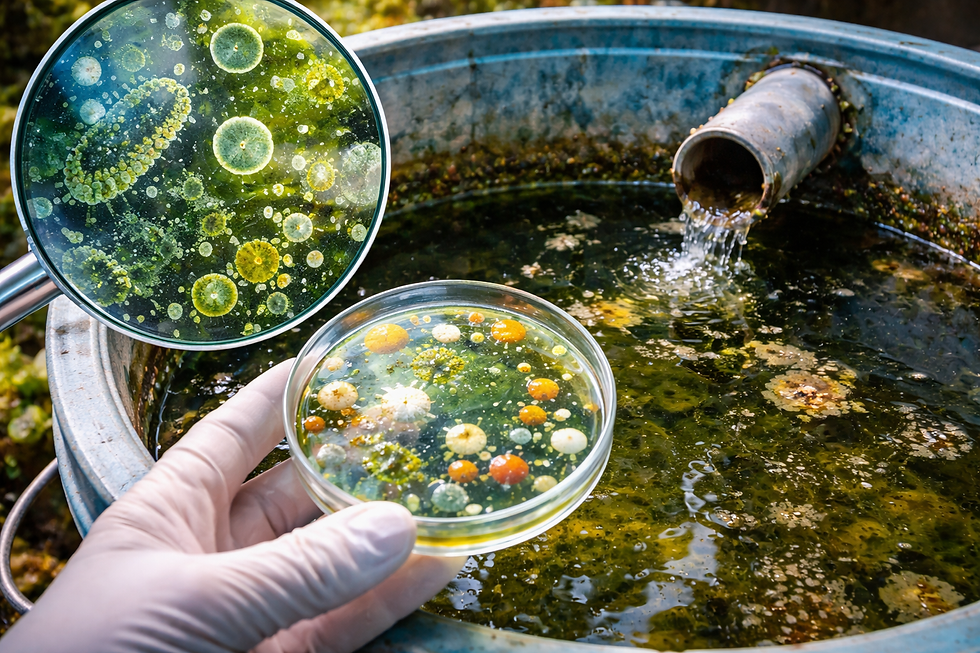

Água Parada e Crescimento de Microrganismos Patogênicos: Implicações Científicas, Sanitárias e Tecnológicas
- Keller Dantara
- 12 de mar.
- 9 min de leitura
Introdução
A água é um recurso essencial para a manutenção da vida e para o funcionamento de praticamente todos os sistemas produtivos e sociais contemporâneos. No entanto, quando permanece estagnada por períodos prolongados, pode se tornar um ambiente altamente favorável ao desenvolvimento de microrganismos patogênicos. Esse fenômeno representa um desafio significativo para áreas como saúde pública, engenharia sanitária, microbiologia ambiental e controle de qualidade em setores industriais.
A presença de água parada em reservatórios, tubulações, caixas d’água, sistemas de climatização, áreas urbanas ou ambientes naturais cria condições propícias para a proliferação de bactérias, vírus, protozoários e fungos capazes de causar doenças em seres humanos e animais. Esses microrganismos encontram na água estagnada nutrientes dissolvidos, temperaturas relativamente estáveis e ausência de fluxos que poderiam dispersar ou limitar seu crescimento. Em tais condições, ocorre frequentemente a formação de biofilmes — comunidades microbianas organizadas que aderem a superfícies e aumentam significativamente a resistência dos microrganismos a agentes desinfetantes.
Nas últimas décadas, a crescente urbanização, aliada à expansão de sistemas complexos de abastecimento de água e à intensificação de atividades industriais, ampliou os contextos nos quais a água parada pode representar um risco microbiológico relevante. Episódios documentados de surtos associados a reservatórios contaminados, torres de resfriamento e sistemas de água predial demonstram que a gestão inadequada desses ambientes pode favorecer a disseminação de patógenos de importância epidemiológica, como Legionella pneumophila, Pseudomonas aeruginosa e diversas espécies de enterobactérias.
Além do impacto direto na saúde pública, a contaminação microbiológica associada à água estagnada também possui implicações relevantes para setores industriais sensíveis à qualidade microbiológica da água, incluindo as indústrias farmacêutica, cosmética, alimentícia e de dispositivos médicos. Nessas áreas, a presença de microrganismos pode comprometer processos produtivos, reduzir a vida útil de produtos e gerar não conformidades regulatórias.
Diante desse cenário, compreender os mecanismos que favorecem o crescimento microbiano em ambientes aquáticos estagnados tornou-se uma questão central para pesquisadores e profissionais que atuam na interface entre microbiologia, engenharia sanitária e gestão da qualidade. O presente artigo aborda, de forma aprofundada, os fatores que contribuem para a proliferação de microrganismos patogênicos em água parada, explorando seu contexto histórico, fundamentos teóricos, impactos científicos e aplicações práticas, além de apresentar metodologias utilizadas para monitoramento e análise microbiológica desses sistemas.
Contexto Histórico e Fundamentos Teóricos
A relação entre água e transmissão de doenças infecciosas tem sido reconhecida há séculos, mas foi apenas a partir do século XIX que os avanços da microbiologia permitiram compreender os mecanismos envolvidos nesse processo. Um marco fundamental ocorreu em 1854, quando o médico britânico John Snow demonstrou que um surto de cólera em Londres estava associado ao consumo de água contaminada de uma bomba pública localizada na Broad Street. Esse episódio é amplamente considerado um dos primeiros exemplos de investigação epidemiológica moderna e estabeleceu as bases para a compreensão da água como veículo de transmissão de patógenos.
Com o desenvolvimento da teoria germinal das doenças por Louis Pasteur e Robert Koch nas décadas seguintes, consolidou-se a ideia de que microrganismos específicos eram responsáveis por diversas enfermidades humanas. A partir desse momento, tornou-se evidente que ambientes aquáticos poderiam servir como reservatórios e meios de disseminação de agentes infecciosos.
Ao longo do século XX, estudos em microbiologia ambiental passaram a demonstrar que a água não é um ambiente biologicamente inerte. Pelo contrário, ela abriga comunidades microbianas complexas capazes de interagir com superfícies, nutrientes dissolvidos e outros organismos. Em ambientes com fluxo reduzido ou inexistente — como reservatórios estagnados ou sistemas hidráulicos pouco utilizados — essas comunidades podem crescer rapidamente e formar biofilmes.
Formação de biofilmes em ambientes aquáticos
Os biofilmes representam um dos mecanismos mais importantes associados à sobrevivência e proliferação de microrganismos em sistemas de água. Trata-se de estruturas formadas por comunidades microbianas que se aderem a superfícies sólidas e produzem uma matriz extracelular composta por polímeros orgânicos, principalmente polissacarídeos, proteínas e ácidos nucleicos.
Essa matriz atua como uma espécie de “escudo biológico”, protegendo os microrganismos contra fatores ambientais adversos, incluindo variações de temperatura, desinfetantes químicos e ação mecânica do fluxo de água. Como consequência, microrganismos presentes em biofilmes podem apresentar resistência significativamente maior a processos de desinfecção quando comparados às formas planctônicas (livres na água).
Sistemas de distribuição de água, especialmente aqueles com zonas de baixa circulação, oferecem condições ideais para o desenvolvimento de biofilmes. Materiais utilizados em tubulações — como PVC, cobre ou aço galvanizado — podem servir como superfícies de adesão para microrganismos, facilitando a colonização microbiana.
Fatores ambientais que favorecem a proliferação microbiana
Diversos fatores ambientais contribuem para o crescimento de microrganismos em água parada. Entre os principais destacam-se:
Disponibilidade de nutrientes orgânicos, como carbono dissolvido;
Temperatura adequada, frequentemente entre 20 °C e 45 °C para muitas bactérias patogênicas;
Baixa circulação da água, que reduz a dispersão microbiana;
Ausência ou degradação de desinfetantes residuais, como cloro livre;
Presença de superfícies sólidas, que facilitam a formação de biofilmes.
Esses fatores podem ocorrer simultaneamente em diversos ambientes artificiais, incluindo caixas d’água residenciais, torres de resfriamento, sistemas de irrigação, piscinas mal mantidas e equipamentos hospitalares.
Marco regulatório e diretrizes sanitárias
A preocupação com a qualidade microbiológica da água levou à criação de normas e regulamentações em diversos países. No Brasil, a Portaria GM/MS nº 888/2021, do Ministério da Saúde, estabelece os padrões de potabilidade da água destinada ao consumo humano e define parâmetros microbiológicos que devem ser monitorados regularmente.
Entre os indicadores microbiológicos mais utilizados estão:
Coliformes totais
Escherichia coli
Enterococos
Bactérias heterotróficas
Esses microrganismos funcionam como indicadores indiretos da qualidade sanitária da água e da possível presença de patógenos.
Organizações internacionais, como a Organização Mundial da Saúde (OMS), a Environmental Protection Agency (EPA) e a International Organization for Standardization (ISO), também publicam diretrizes e normas voltadas ao monitoramento microbiológico de sistemas hídricos.
Importância Científica e Aplicações Práticas
A compreensão do crescimento microbiano em água parada possui implicações diretas em diversos setores científicos e industriais. A seguir são discutidas algumas das principais áreas impactadas por esse fenômeno.
Saúde pública e vigilância epidemiológica
A contaminação microbiológica de sistemas de água pode resultar em surtos de doenças transmitidas pela água, conhecidos como waterborne outbreaks. Esses eventos podem ocorrer quando microrganismos patogênicos presentes em água contaminada são ingeridos ou inalados na forma de aerossóis.
Um exemplo amplamente documentado é a legionelose, doença respiratória causada pela bactéria Legionella pneumophila. Essa bactéria pode proliferar em sistemas de água morna, especialmente em torres de resfriamento e sistemas de ar condicionado. Quando a água contaminada é aerossolizada, as bactérias podem ser inaladas, causando infecções pulmonares graves.
Estudos epidemiológicos indicam que surtos de legionelose frequentemente estão associados a sistemas de água mal mantidos ou com baixa circulação.
Indústria farmacêutica
No setor farmacêutico, a qualidade microbiológica da água é um parâmetro crítico para a produção de medicamentos, especialmente aqueles administrados por via parenteral ou utilizados em processos assépticos.
Sistemas de água purificada e água para injetáveis são projetados para minimizar o crescimento microbiano. Entretanto, mesmo nesses sistemas, zonas de estagnação podem favorecer a formação de biofilmes e a proliferação de microrganismos.
Diretrizes internacionais, como as Good Manufacturing Practices (GMP) e documentos da United States Pharmacopeia (USP), estabelecem limites rigorosos para a contagem microbiológica da água utilizada em processos farmacêuticos.
Indústria alimentícia
Na indústria de alimentos, a água é amplamente utilizada em processos de lavagem, processamento e formulação de produtos. Caso esteja contaminada, pode atuar como vetor de microrganismos patogênicos responsáveis por doenças transmitidas por alimentos.
Bactérias como Salmonella, Listeria monocytogenes e Escherichia coli podem sobreviver em ambientes aquáticos e contaminar superfícies de processamento, equipamentos e matérias-primas.
Consequentemente, sistemas de gestão de segurança alimentar — como o HACCP (Hazard Analysis and Critical Control Points) — incluem a qualidade microbiológica da água como um ponto crítico de controle.
Sistemas urbanos e infraestrutura hídrica
Em ambientes urbanos, a presença de água parada em sistemas de drenagem, reservatórios e estruturas abandonadas pode contribuir não apenas para o crescimento de microrganismos, mas também para a proliferação de vetores de doenças, como mosquitos.
Além disso, redes de distribuição de água potável podem apresentar áreas de baixa circulação hidráulica, conhecidas como zonas mortas, nas quais o cloro residual pode se degradar rapidamente, permitindo o crescimento bacteriano.
Estudos realizados em sistemas de abastecimento demonstram que a manutenção adequada da circulação da água e o controle do desinfetante residual são fatores críticos para evitar a colonização microbiana.
Metodologias de Análise
A avaliação microbiológica da água envolve uma série de técnicas laboratoriais padronizadas utilizadas para detectar, identificar e quantificar microrganismos presentes em amostras ambientais.
Métodos microbiológicos clássicos
Entre os métodos mais amplamente utilizados estão as técnicas de cultura microbiológica em meios seletivos e diferenciais.
A contagem de bactérias heterotróficas, por exemplo, é frequentemente realizada utilizando o método de plate count, no qual amostras de água são inoculadas em placas de ágar e incubadas por períodos específicos.
Outras técnicas incluem:
Filtração por membrana, amplamente utilizada para detectar coliformes;
Número Mais Provável (NMP), método estatístico utilizado para estimar a concentração de microrganismos;
Cultivo em meios cromogênicos, que facilitam a identificação de espécies bacterianas.
Esses métodos são descritos em manuais técnicos como o Standard Methods for the Examination of Water and Wastewater (SMWW).
Métodos moleculares
Nos últimos anos, técnicas baseadas em biologia molecular passaram a complementar os métodos tradicionais.
Entre as principais destacam-se:
PCR (Reação em Cadeia da Polimerase) para detecção de DNA microbiano;
qPCR (PCR quantitativo) para quantificação precisa de patógenos;
Sequenciamento de nova geração (NGS) para análise de comunidades microbianas complexas.
Essas tecnologias permitem detectar microrganismos que não crescem facilmente em cultura, ampliando significativamente a capacidade de monitoramento microbiológico.
Limitações e desafios
Apesar dos avanços tecnológicos, a análise microbiológica da água ainda apresenta desafios importantes. Entre eles destacam-se:
variabilidade natural das comunidades microbianas;
dificuldade de detectar patógenos em concentrações muito baixas;
presença de microrganismos viáveis, mas não cultiváveis.
Por esse motivo, muitos programas de monitoramento combinam diferentes metodologias para obter resultados mais robustos.
Considerações Finais e Perspectivas Futuras
A presença de água parada em sistemas naturais e artificiais representa um fator crítico para o crescimento de microrganismos patogênicos e para o desenvolvimento de biofilmes microbianos. Esse fenômeno possui implicações relevantes para a saúde pública, para a segurança alimentar e para a qualidade de processos industriais que dependem de água microbiologicamente controlada.
Ao longo das últimas décadas, avanços significativos em microbiologia ambiental, engenharia sanitária e tecnologias analíticas permitiram compreender com maior precisão os mecanismos que favorecem a proliferação microbiana em ambientes aquáticos estagnados. No entanto, o controle efetivo desse fenômeno continua a depender de estratégias integradas que envolvam monitoramento constante, manutenção adequada de sistemas hidráulicos e aplicação rigorosa de normas sanitárias.
No contexto científico, novas ferramentas de análise molecular e abordagens baseadas em metagenômica prometem ampliar ainda mais a capacidade de identificação e caracterização de comunidades microbianas em sistemas de água. Essas tecnologias podem contribuir para o desenvolvimento de estratégias mais eficazes de prevenção e controle da contaminação microbiológica.
Do ponto de vista institucional e industrial, a adoção de boas práticas de gestão da água — incluindo o controle da circulação hidráulica, a manutenção de níveis adequados de desinfetantes residuais e a limpeza periódica de reservatórios — continuará sendo um elemento central para reduzir riscos microbiológicos.
Em um cenário global marcado pelo crescimento urbano, pelas mudanças climáticas e pela intensificação das demandas sobre recursos hídricos, o estudo do comportamento microbiológico da água parada torna-se cada vez mais relevante. Investimentos em pesquisa, inovação tecnológica e políticas públicas voltadas à segurança hídrica serão fundamentais para garantir que a água continue sendo um recurso seguro e sustentável para as próximas gerações.
A Importância de Escolher a Polaris Análises
Com anos de experiência no mercado, a Polaris Análises possui um histórico comprovado de sucesso em análises laboratoriais.
Empresas do setor alimentício, indústrias farmacêuticas, laboratórios e outros segmentos confiam na Polaris Análises para garantir a segurança e qualidade da água utilizada em suas atividades.
Evitar riscos de contaminação é um compromisso com a saúde de seus clientes e com a longevidade do seu negócio. Investir em análises periódicas é um diferencial que fortalece sua reputação e evita prejuízos futuros.
Para saber mais sobre os serviços da Polaris Análises - Análises de Ar, Água, Alimentos, Swab e Efluentes ligue para (11) 91776-7012 (WhatsApp) ou clique aqui e solicite seu orçamento.
❓ FAQs – Perguntas Frequentes
1. Por que a água parada favorece o crescimento de microrganismos patogênicos?
A ausência de circulação cria condições estáveis que favorecem a proliferação microbiana. Nutrientes dissolvidos, temperatura relativamente constante e baixa turbulência permitem que bactérias, fungos e protozoários se multipliquem com maior facilidade e formem biofilmes em superfícies como tubulações, reservatórios e caixas d’água.
2. Quais microrganismos podem se desenvolver em água estagnada?
Diversos microrganismos podem colonizar ambientes aquáticos parados, incluindo bactérias como Legionella pneumophila e Pseudomonas aeruginosa, além de coliformes, fungos e protozoários. A presença desses organismos pode representar risco sanitário, especialmente em sistemas de abastecimento, ambientes hospitalares e instalações industriais.
3. A formação de biofilmes influencia o crescimento microbiano na água?
Sim. Biofilmes são comunidades microbianas aderidas a superfícies que produzem uma matriz protetora composta por substâncias orgânicas. Essa estrutura aumenta a resistência dos microrganismos a desinfetantes e facilita sua persistência em sistemas hidráulicos, especialmente em áreas com fluxo reduzido ou água parada.
4. Água parada em reservatórios domésticos pode representar risco à saúde? Pode. Reservatórios mal vedados, pouco higienizados ou com baixa renovação de água podem favorecer o crescimento de microrganismos. Por esse motivo, recomenda-se limpeza periódica das caixas d’água e manutenção adequada dos sistemas de armazenamento e distribuição.
5. Como a qualidade microbiológica da água parada é avaliada em laboratório?
A avaliação envolve análises microbiológicas específicas, como contagem de bactérias heterotróficas, detecção de coliformes totais e Escherichia coli, além de métodos moleculares como PCR. Essas análises seguem protocolos estabelecidos em normas técnicas internacionais, como o Standard Methods for the Examination of Water and Wastewater.
6. É possível prevenir o crescimento de microrganismos em sistemas de água?
Sim. Medidas preventivas incluem manter a circulação da água, evitar zonas de estagnação em tubulações, realizar desinfecção adequada, controlar níveis de cloro residual e executar programas regulares de monitoramento microbiológico. Essas práticas são fundamentais para reduzir riscos sanitários em ambientes domésticos, industriais e institucionais.
_edited.png)



Comentários